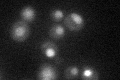
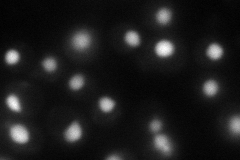
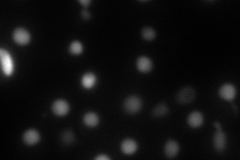
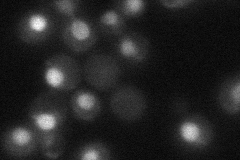

View description
B subunit of DNA polymerase alpha-primase complex, required for initiation of DNA replication during mitotic and premeiotic DNA synthesis; also functions in telomere capping and length regulation
Localization:
Intensity:
Fold change:
Significance:
-
C’ GFP library in SD
nucleus30.2 -
N' NOP1pr-GFP in SD
nucleus68.7119 -
N' TEF2pr-mCherry in SD
nucleus55.1726 -
N' NATIVEpr-GFP in SD
nucleus42.5234 -
N' TEF2pr-VC and Cyto-VN in SD

nucleus37.6887 -
C’ GFP library in SD+DTT

nucleus31.571.04No -
C’ GFP library in SD+H2O2

nucleus34.861.15No -
C’ GFP library in Starvation Media

nucleus17.210.56Yes -
C’ GFP library on the background of Pup2-DaMP

nucleus -
C’ GFP library on the background of CCT mutant

nucleus29.43940.974632No
